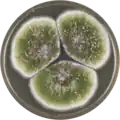
Aspergillus sergii growing on MEAOX plate

Aspergillus sergii
| Aspergillus sergii | |
|---|---|
| Scientific classification | |
| Kingdom: | Fungi |
| Division: | Ascomycota |
| Class: | Eurotiomycetes |
| Order: | Eurotiales |
| Family: | Aspergillaceae |
| Genus: | Aspergillus |
| Species: | A. sergii
|
| Binomial name | |
| Aspergillus sergii P. Rodrigues, S.W. Peterson, Venâncio & N. Lima[1]
| |
Aspergillus sergii is a species of fungus in the genus Aspergillus first isolated from almonds and maize in Portugal.[1] It is from the Flavi section.[1] It has been reported to produce aflatoxin G, aflatoxin B, and cyclopiazonic acid.[1]
Growth and morphology
A. sergii has been cultivated on both Czapek yeast extract agar (CYA) plates and Malt Extract Agar Oxoid® (MEAOX) plates. The growth morphology of the colonies can be seen in the pictures below.
-
 Aspergillus sergii growing on CYA plate
Aspergillus sergii growing on CYA plate -
Aspergillus sergii growing on MEAOX plate
Aspergillus sergii growing on MEAOX plate
References
Further reading
- Soares C, Peterson S, Rodrigues P, Lima N, Venâncio A (2011). "Three new aflatoxigenic species of Aspergillus section Flavi isolated in Portugal". Book of Abstracts of the ECCOXXX–30th Annual Meeting of the European Culture Collection Organisation. CBS. hdl:10198/10130.